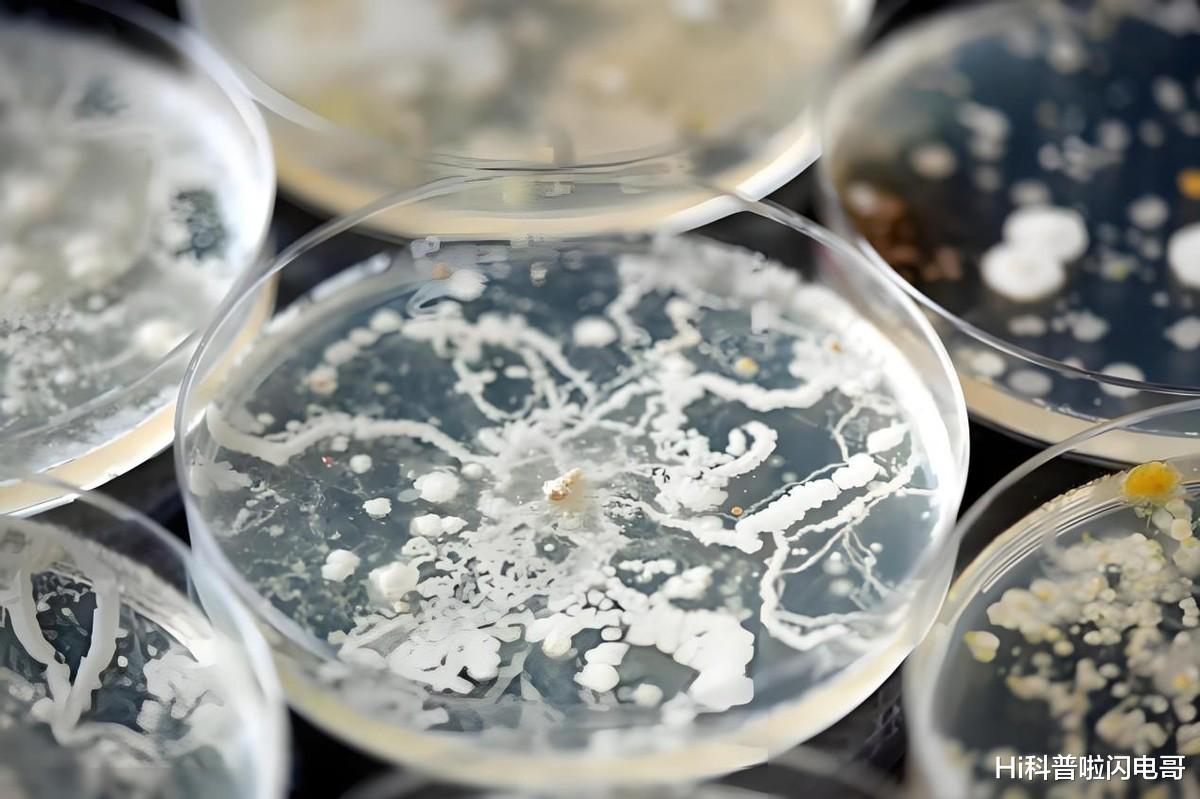

青藏高原一直牛配资,这个被称为"世界屋脊"的地方,升温速度达到全球平均水平的2倍!并且加速了冰川融化,高原上的湖泊正以肉眼可见的速度扩张。这不仅是个气候现象,更是一场影响中印两国十多亿人口的危机。

高原湖泊为何发福
色林错湖泊已经从1000平方公里膨胀到了2400平方公里,面积竟然翻了一倍多!
这不是个例,青藏高原上的湖泊普遍在膨胀。1995-2022年间,高原湖泊总面积增长了26.6%,达到46980平方公里,增加的水量高达170亿吨。
为什么湖泊会这样扩张?这背后是四大因素的合谋:首先,气温升高是罪魁祸首。青藏高原的升温速率达到全球平均的2倍,堪称气候变化的放大器。
高温就像一把无形的火,加速冰川消融。过去几十年,高原上的冰川以惊人的速度退缩,释放出大量淡水。

其次是降水模式发生了变化。气象站记录显示,高原地区夏季降水量增加了约20%。想象一下,原本干燥的高原现在频繁下起了大雨,这些额外的雨水自然流入了湖泊。
第三是冻土在融化。高原下面有厚厚的冻土层,储存着大量冰水。随着气温升高,这些冻土开始融化,释放出长期封存的水分。

最后,青海湖也不甘示弱,2000-2021年间面积扩大了370平方公里。有意思的是,高原北部湖泊的扩张速度最快,这与那里气温升高更显著有关。
这些湖泊扩张不是简单的水多了点,而是一个错综复杂的生态系统正在发生根本性改变。气候变化之手,正在重塑这片神秘高原的面貌。
一直牛配资
湖泊扩张的福祸两面
对中国而言,湖泊扩张是把双刃剑,既有甜头也有苦果。
先说好处。青藏高原是长江、黄河等大江大河的源头,这些扩大的湖泊就像天然的水库,增加了下游的水资源储备。
当南方某地干旱时,融化的冰川水可能正好补充了江河的水量,缓解了缺水危机。这些湖泊调节水流,减缓了季节性洪水的冲击,为水资源管理提供了缓冲。

但问题也不少。首先是生态破坏。湖水上涨淹没了大片草地,藏羚羊等野生动物的栖息地被迫缩减。这些动物不得不寻找新家园,生态系统的平衡被打破。
更令人担忧的是,冻土融化威胁着青藏铁路等基础设施的安全。冻土是高原上建筑的地基,它融化后,地面会不均匀下沉,就像房子的地基突然变软了,后果可想而知。

灾害风险也在上升。2018年,扎日南木错湖发生溃堤事件,造成数千万元的经济损失。专家预测,随着湖泊继续扩张,未来类似的决堤风险将会加剧。
此外,湖泊扩张也给水利管理带来了新挑战。以三峡工程为例,它需要应对更为复杂的水量波动。上游水量突然增加,下游可能面临洪水风险;水量突然减少,又可能影响发电和航运。

跨境连锁反应
当青藏高原的冰雪融化,流出的不仅是水,还有一系列跨境问题。对印度来说一直牛配资,这些问题尤为严重。
最直接的是洪水威胁。布拉马普特拉河(在中国境内称为雅鲁藏布江)流经印度东北部的阿萨姆邦。
2020年,该地区遭遇特大洪灾,数百万人被迫撤离家园,经济损失高达数十亿美元。这些洪水与上游冰川融水增加直接相关。

洪水过后是农业危机。恒河流域是印度的粮仓,但灌溉水量的不稳定导致比哈尔邦等地粮食减产。
据统计,印度东北部约30%的农田受到洪涝影响,农民收入大幅下降。这对一个有14亿人口的国家来说,粮食安全是头等大事。
更棘手的是地缘政治问题,雅鲁藏布江水量变化加剧了中印水资源分配争议。
印度媒体经常炒作中国水威胁论,声称中国上游的水资源开发影响了印度的用水安全。这种言论在两国关系紧张时期尤为常见,给双边关系蒙上阴影。

冰雪消融的深层危机
除了看得见的湖泊扩张和洪水风险,青藏高原的变化还隐藏着更深层次的危机。
首先是印度应对能力的不足。印度缺乏高精度的水文预警系统,2021年北阿坎德邦发生的冰川断裂事件导致200多人死亡,暴露出监测系统的严重漏洞。
此外,印度的防洪设施建设滞后,阿萨姆邦70%的村庄没有防洪堤,每年汛期都面临生命威胁。

国际合作也存在瓶颈。目前中印之间的水文数据共享仅限于汛期基本流量通报,缺乏深入的联合研究项目。这种信息孤岛状态使得两国难以协同应对共同面临的水资源挑战。
更令人担忧的是冻土融化带来的次生危机。科学家估计,青藏高原冻土中含有约1650亿吨有机碳。

随着冻土融化,这些碳以甲烷等温室气体形式释放,可能引发气候变暖的正反馈循环——更暖的气温导致更多冻土融化,释放更多温室气体,进而导致气温进一步升高。
此外,冻土中还封存着古代微生物。据研究,一些在冻土融化后释放的未知病原体已在下游恒河水系中被检测到。这些沉睡数千年的微生物可能对现代人类免疫系统构成挑战,潜在引发公共卫生危机。
应对共同挑战的必由之路
面对青藏高原的变化,中印两国必须抛开分歧,共同应对。这不是外交辞令,而是地理现实决定的必然选择。
两国应建立更全面的联合水文监测站网络,实时交换雅鲁藏布江等跨境河流的流量数据。中印两国在2013年签署的水文报汛协议是个良好开端,但范围和深度都有待扩展。
工程协同也很关键。中印可以参考美国-墨西哥在科罗拉多河管理方面的合作模式,共建跨境防洪设施,如联合水库调节系统,平衡上下游水资源分配。

生态治理同样重要。联合修复喜马拉雅南麓湿地,可以有效降低洪水冲击。湿地就像天然的"海绵",能够吸收洪峰,减缓水流。
更宏大的愿景是推动建立"亚洲水塔多边委员会",纳入巴基斯坦、孟加拉国等下游国家,共同制定区域性水资源管理方案。
毕竟,水不认国界,解决方案也不应局限于双边框架。青藏高原不只是中国的屋脊一直牛配资,也是亚洲的水塔。
文商期货配资提示:文章来自网络,不代表本站观点。